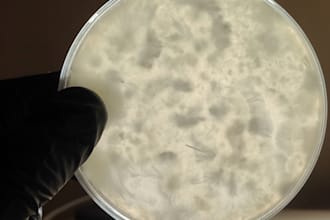
do anything around mushrooms

Explorar las categorías
- Tendencias 🔥Tendencias 🔥
- Publica tu libro
- Diseño de libros
- Edición de libros
- Marketing de libros y libros electrónicos
- Ilustraciones de libros infantiles
- Lector beta
- Convertir a libro electrónico
- Escritura de libros electrónicos
- Crea tu marca
- Estrategia de marcaNuevo
- Guías de estilo para marcas
- Administración de redes sociales
- Diseños para medios sociales
- Videos UGC
- Anuncios y comerciales en video
- Redes sociales pagas
- Aumenta tu público
- Estrategias de medio sociales
- Videos en redes sociales
- Explicaciones con imágenes reales
- Videos de diapositivas
- Promoción en redes sociales
- Automatización de redes sociales
- Artes gráficas y diseñoArtes gráficas y diseño
- Logo e identidad de marca
- Diseño de logos
- Guías de estilo para marcas
- Tarjetas de presentación y papelería
- Fuentes y tipografía
- Dirección de arteNuevo
- Herramienta Logo Maker
- Arte e ilustraciones
- Ilustraciones
- Artistas de IA
- Diseño de avatar de IANuevo
- Retratos y caricaturas
- Ilustraciones de cómicsNuevo
- Ilustración de dibujos animados
- Storyboards
- Diseño de portada de álbumes
- Diseño de patrones
- Diseño de tatuajes
- Varios
- Consejos de diseño
- Diseño de aplicaciones y sitios web
- Diseño web
- Diseño de aplicaciones
- Diseño UX
- Diseño de landing page
- Diseño de íconos
- Producto y gaming
- Diseño industrial y de productos
- Modelado de personajes
- Game art
- Artes gráficas para Streamers
- Diseño de impresión
- Diseño de folletos
- Diseño de flyers
- Diseño de packaging y etiquetas
- Diseño de pósteres
- Diseño de catálogos
- Diseño de menús
- Libros y eBooks
- Diseño de libros
- Portadas de libros
- Diseño y composición de libros
- Ilustraciones de libros infantiles
- Ilustración de cómicsNuevo
- Diseño visual
- Edición de imágenes
- Edición de imágenes con IANuevo
- Diseño de presentaciones
- Diseño de currículums
- Diseño de infografías
- Vectorización
- Diseño de marketing
- Diseños para redes sociales
- Diseño de correo electrónico
- Banners web
- Diseño de carteles
- Arquitectura y diseño de construcción
- Arquitectura y diseño de interiores
- Paisajismo
- Ingeniería de edificación
- Diseño de iluminación
- Moda y merchandise
- Camisetas y artículos de promoción
- Diseño de moda
- Diseño de joyas
- Programación y tecnol.Programación y tecnol.
- Desarrollo de sitios web
- Sitio web comercial
- Desarrollo de e-commerce
- Sitios web personalizados
- Landing pages
- Sitios web Dropshipping
- Mantenimiento del sitio web
- Personalización del sitio web
- Corrección de errores
- Copia de seguridad y migración
- Optimización de velocidad
- Idiomas y marcos
- Python
- React
- Java
- React Native
- Flutter
- Desarrollo de IA
- Sitios web y software con IANuevo
- Aplicaciones móviles de IANuevo
- Integraciones de IA
- Automatizaciones y agentes de IA
- Perfeccionamiento de la IA
- Consultoría tecnológica con IANuevo
- Codificación de vibraciones
- Desarrollo y MVPNuevo
- Solución de problemas y mejorasNuevo
- Implementaciones y DevOpsNuevo
- Desarrollo de aplicaciones móviles
- Desarrollo multiplataforma
- Desarrollo de aplicaciones para Android
- Desarrollo de aplicaciones para iOS
- Mantenimiento de aplicaciones móviles
- Nube y ciberseguridad
- Cloud Computing
- DevOps Engineering
- Cybersecurity
- Marketing digitalMarketing digital
- Posicionamiento en buscadores
- Posicionamiento web (SEO)
- Optimización del motor generativoNuevo
- Marketing de motores de búsqueda (SEM)
- SEO local
- SEO para E-commerce
- SEO de video
- Redes sociales
- Marketing para redes sociales
- Redes sociales pagas
- Comercio en redes sociales Nuevo
- Marketing de influencia
- Comunidades en línea
- Específico de canal
- TikTok Shop
- Campaña de Facebook Ads
- Marketing en instagram
- Promoción de YouTube
- Google SEM
- marketing shopify
- Métodos y técnicas
- Video marketing
- Marketing para e-commerce
- Email marketing
- Automatizaciones de correo electrónico
- Automatizaciones de marketing
- Publicación de invitados
- Marketing de afiliados
- Publicidad display
- Relaciones públicas
- Crowdfunding
- SMS Marketing
- Escala tu marketing con IA
- Estrategia de prompts de IA para marketing
- Diseño de personalidad de marca
- Personalización de email marketing
- Gestión de campañas impulsada por IA
- Automatización y licitaciones de anuncios impulsadas por IA
- Video y animaciónVideo y animación
- Edición y postproducción
- Edición de video
- Efectos visuales
- Videos de intros y outros
- Reutilización de videos
- Edición de plantillas de video
- Subtítulos y leyendas
- Videos sociales y de marketing
- Anuncios y comerciales en video
- Videos en redes sociales
- Videos musicales
- Videos de diapositivas
- Déjanos gestionar tu proyecto
- Videos de presentador
- Videos UGC
- Videos de UGC para TikTok
- Videos UGC para Instagram
- Videos de presentadores
- Gráficos animados
- Animación de logos
- Lottie y Animación web
- Animación de texto
- Videoarte
- Animación
- Animación de personajes
- GIF animados
- Animación para niños
- Animación para Streamers
- Montaje
- Animación de NFT
- Producción cinematográfica
- Camarógrafos
- Videografía con dronesNuevo
- Producción cinematográfica
- Videos explicativos
- Video explicativo animado
- Explicaciones con imágenes reales
- Screencasting
- Producción de video de eLearning
- Videos de crowdfunding
- Videos de productos
- Animación de productos en 3D
- Videos de productos para e-commerce
- Videos corporativos
- Vistas previas de aplicaciones y sitios web
- Escritura y traducciónEscritura y traducción
- Redacción de contenido
- Artículos y blogs
- Estrategia de contenidoNuevo
- Contenido para sitios web
- Redacción de guiones
- Escritura creativa
- Redacción de pódcast
- Redacción de discursos
- Investigación y resúmenes
- Encuentra un escritor experto
- Edición y crítica
- Corrección y edición de textos
- Apoyo académico Nuevo
- Edición de contenido de IA
- Consejos de escritura
- Libros y libros electrónicos
- Escritura de libros electrónicos
- Edición de libros
- Lector beta
- Traducción de libros y traducción literaria
- Autopublica tu libro
- Redacción profesional
- Redacción de currículums
- Cartas de presentación
- Perfiles de LinkedIn
- Descripciones de puestos de trabajo
- Contenido para negocios y marketing
- Tono de voz de la marca
- Nombres comerciales y eslóganes
- Estudio de casos
- Descripciones de productos
- Texto del anuncio
- Texto para ventas
- Texto para correos electrónicos
- Redacción creativa en redes sociales
- Comunicados de prensa
- UX Writing
- Traducción y transcripción
- Traducción
- LocalizaciónNuevo
- Transcripción
- InterpretaciónNuevo
- Contenido específico de la industria
- Negocios, finanzas y derecho
- Salud y medicina
- Internet y tecnología
- Noticias y política
- Marketing
- Bienes Raíces
- Música y audioMúsica y audio
- Producción y escritura musical
- Productores de música
- Compositores
- Cantantes y vocalistas
- Músicos de sesión
- Compositores de canciones
- Jingles e introducciones
- Canciones personalizadasNuevo
- Déjanos gestionar tu proyecto
- Voz en off y narración
- Entrega en 24 horas
- Voice over de mujer
- Voice over de hombre
- Voice over en francés
- Voice over en alemán
- Ingeniería de audio y posproducción
- Mezcla y masterización
- Edición de audio
- Afinación vocal
- Streaming y audio
- Producción de pódcast
- Producción de audiolibros
- Producción de anuncios de audio
- Síntesis de voz e IA
- Diseño de sonido
- Diseño de sonido
- Música de meditación
- Audio Logo y Sonic Branding
- Parches y muestras personalizadas
- Desarrollo de complementos de audio
- Lecciones y transcripciones
- Clases de música en línea
- Transcripción de música
- Consejos de música y audio
- NegociosNegocios
- Constitución de empresas y consultoría
- Registro de LLC
- Constitución y registro de empresasNuevo
- Estudio de mercado
- Planes de negocios
- Consultoría de negocios
- Consultoría en RR. HH.
- Consultoría de IA
- Operaciones y gestión
- Asistente virtual
- Gestión de proyectos
- Gestión de software
- Gestión de comercio electrónico
- Gestión de la cadena de suministro
- Asesoramiento sobre aduanas y arancelesNuevo
- Gestión de eventos
- Gestión de producto
- Servicios jurídicos
- Gestión de propiedad intelectualNuevo
- Contratos y documentos legales
- investigación legal
- Asesoría legal general
- Ventas y atención al cliente
- Ventas
- Gestión de experiencia del cliente (CXM)Nuevo
- Generación de leads
- Ingeniería GTMNuevo
- Atención al cliente
- FinanzasFinanzas
- Servicios de contabilidad
- Servicios de CFO fraccionados
- Informes financieros
- Auditoría de libros
- Gestión de nóminas
- Encuentra un experto en finanzas
- Finanzas corporativas
- Diligencia debida
- Valoración
- Asesoría en fusiones y adquisiciones
- Estrategia de finanzas corporativas
- Consultoría fiscal
- Declaraciones de impuestos
- Servicios de identificación fiscal
- Planificación fiscal
- Cumplimiento tributario
- Exenciones fiscales
- Planificación y análisis financiero
- Presupuesto y previsiones
- Modelos financieros
- Análisis de costos
- Análisis de acciones
- Finanzas personales y gestión patrimonial
- Gestión de presupuesto personal
- Asesoría de inversiones
- Cursos en línea de Operaciones bursátiles
- Asesoría sobre jubilación
- Coaching financiero
- Asesoría en seguros
- Servicios de IAServicios de IA
- Desarrollo de aplicaciones móviles con IA
- Aplicaciones móviles de IANuevo
- Sitios web y software con IANuevo
- Chatbots de IA
- Integraciones de IA
- Automatizaciones y agentes de IA
- Perfeccionamiento de la IA
- Consultoría tecnológica con IANuevo
- Déjanos gestionar tu proyecto
- Artistas de IA
- Diseño de avatar de IANuevo
- Creación de flujos de trabajo ComfyUI
- Edición de imágenes con IANuevo
- Artistas de Midjourney
- Artistas de Stable Diffusion
- Todos los Servicios de AI Art
- IA para negocios
- Consultoría de IA
- Estrategia de IA
- Lecciones de IA
- Audio con IA
- Síntesis de voz e IA
- Texto a voz
- Crecimiento personalCrecimiento personal
- Superación personal
- Tutoría en línea
- Clases de idiomas
- Coaching de vida
- Orientación profesional
- Clases de IA generativa
- Videojuegos
- Coaching de juegos
- Coaching para Marvel RivalsNuevo
- Estrategia y gestión de eSports
- Búsqueda de partidasNuevo
- Creaciones dentro del videojuego
- Experiencia en videojuegos y comentariosNuevo
- Grabaciones y guías para videojuegos
- ConsultoríaConsultoría
- Consultores empresariales
- Consultoría jurídica
- Consultoría de negocios
- Consultoría en RR. HH.
- Consultoría de IA
- Planes de negocios
- Consultoría de e-commerce
- Estrategia de marketing
- Estrategia de marketing
- Estrategia de contenido
- Estrategias de medio sociales
- Estrategia de influencers
- Consultoría de Video Marketing
- Estrategia de SEM
- Estrategia de relaciones públicas
- Consultoría de datos
- Consultoría de Data Analytics
- Consultoría de bases de datos
- Consultoría de Visualización de datos
- Coaching y asesoramiento
- Orientación profesional
- Coaching de vida
- Coaching de juegos
- Consejos de estilo y belleza
- Consejos de viaje
- Capacitación nutricionalNuevo
- Coaching de mindfulnessNuevo
- Viajes
- DatosDatos
- Ciencia de datos y aprendizaje automático
- Aprendizaje automáticoNuevo
- Visión Artificial
- PLN
- Deep learning
- Modelos generativos
- Análisis de series temporales
- Análisis y visualización de datos
- Análisis de datos
- Visualización de datos
- Etiquetado y anotación de datos
- Panel de datos
- Recopilación de datos
- Entrada de datos
- Digitación de datos
- Extracción de datos
- Formato de datos
- Limpieza de datos
- Mejora de datosNuevo
- Gestión de datos
- Procesamiento de datos
- Administración y protección de datos
- Bases de datos e ingeniería
- Bases de datos
- Ingeniería de datos
- FotografíaFotografía
- Productos y estilo de vida
- Fotógrafos de productos
- Fotógrafos de alimentos
- Fotógrafos de estilo de vida y de moda
- Personas y escenas
- Fotógrafos de retratos
- Fotógrafos de eventos
- Fotógrafos de propiedades
- Fotógrafos escénicos
- Fotógrafos con drones Nuevo